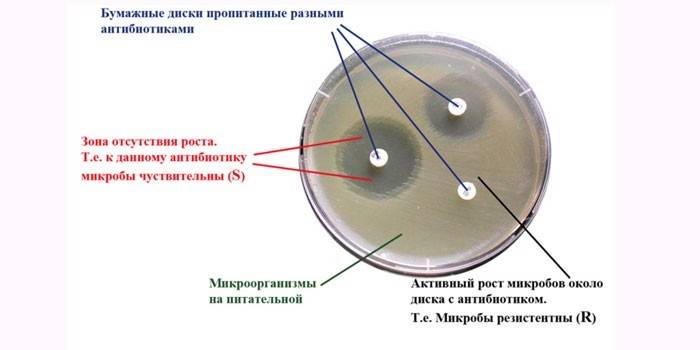

Balanopostite em homem ou criança - sintomas e tratamento
- 1. O que é balanopostite?
- 1.1. Como a doença é diferente da balanite?
- 1.2. A inflamação do prepúcio é perigosa
- 2. Classificação de patologia
- 3. Sintomas de balanopostite
- 3.1. Balanopostite simples
- 4. Causas da inflamação do prepúcio em homens
- 5. Diagnóstico
- 6. Tratamento de balanopostite
- 6.1. Terapia medicamentosa
- 6.2. Intervenção cirúrgica para balanopostite
- 7. Remédios populares para inflamação do prepúcio
- 8. Prevenção
- 9. Vídeo
Uma doença inflamatória que afeta a cabeça e a pele do pênis ocorre em 3% dos homens não circuncidados de diferentes idades. Balanopostite é aguda ou crônica. Para prevenir a ocorrência de complicações, é necessário fazer um diagnóstico oportuno e iniciar o tratamento.
O que é balanopostite?
Os genitais masculinos são constantemente expostos ao meio ambiente. Eles são facilmente inflamados pelo contato com agentes agressivos, vírus, bactérias, alérgenos.
Clinicamente, a patologia se manifesta por dor, inchaço, coceira na região da virilha. Como os genitais de um homem parecem com uma doença podem ser vistos na foto. Balanopostite é diagnosticada em homens não circuncidados: caso contrário, o prepúcio está ausente.

Como a doença é diferente da balanite?
Se a inflamação cobre apenas a glande, é balanite. Esta doença geralmente ocorre devido ao acúmulo de secreção sob a folha externa da carne e é diagnosticada em meninos quando o pênis está completamente coberto de pele. Os sintomas da balanite são semelhantes aos da balanopostite.
A inflamação do prepúcio é perigosa
O processo patológico, por vezes, afeta a uretra, o que leva ao desenvolvimento de uretrite. Dor intensa ocorre quando se tenta ir ao banheiro, o volume diário de urina diminui.Sem tratamento, a balanopostite aguda flui para uma forma crônica e contribui para o aparecimento de tais complicações:
- linfadenite inguinal - inflamação dos gânglios linfáticos;
- urosepsis - intoxicação grave do corpo;
- fimose - estreitamento do prepúcio;
- diminuição da sensibilidade da cabeça do pênis;
- falta de desejo sexual;
- disfunção sexual.

Classificação patológica
Dependendo das causas da inflamação, a balanopostite é dividida em tais tipos:
- Herpético Ocorre no contexto do herpes genital.
- Alérgico Aparece quando os órgãos genitais entram em contato com substâncias agressivas na lavagem de pós, sabão, gel de banho.
- Infeccioso. A inflamação se desenvolve quando uma combinação de condições favoráveis e a presença de vírus, infecções no sangue ou na pele de um homem.
- Tóxico. Aparece com exposição prolongada à pele de toxinas ou depois de tomar medicação. É raramente diagnosticado.
Pela natureza do curso, as balanopostites agudas e crônicas são diferenciadas. O último tipo é dividido em várias subespécies:
- Indutivo É caracterizada pelo enrugamento do prepúcio e da cabeça do pênis.
- Hipertrófica Ulcerativa. Feridas que não cicatrizam e úlceras dolorosas aparecem no corpo, deformação da cabeça ou todo o pênis ocorre.

Sintomas de balanopostite
Com inflamação genital, alguns homens experimentam dor aguda, sensação de queimação durante a micção, outros não têm queixas. A natureza e intensidade das manifestações clínicas dependem do estágio de desenvolvimento da doença. Balanopostite aguda é dividida em 3 tipos:
- simples;
- erosivo;
- gangrenosa.

Balanopostite simples
Desenvolve-se depois do contato com substâncias irritantes não-específicas ou quando as regras de higiene pessoais não se seguem.
- inchaço
- pele seca;
- placa cinzenta branca ou suja sob a cabeça;
- sensações dolorosas;
- vermelhidão ou cor azul da pele;
- retenção urinária;
- fimose.
Erosivo
A balanopostite por candidíase se desenvolve quando infectada com uma levedura do gênero Candida. A doença prossegue em várias etapas:
- Na fase inicial, inchaço, irritação e vermelhidão dos tecidos moles aparecem. Há dor ao tocar os genitais, problemas com a micção.
- No segundo estágio, pequenas manchas vermelhas aparecem na cabeça do pênis, corrimento curado da uretra com um odor desagradável. Coceira, sensação de queimação durante a micção. Os sintomas inespecíficos da inflamação também ocorrem: febre, calafrios, fraqueza geral, perda de apetite.
- Se não for tratada, a erosão se forma no local da erupção. Quando a ferida é pressionada, começa a sangrar, a dor aguda e o exsudado inflamatório aparecem.

Gangrenoso
Esta é uma forma grave da doença. No local da erosão, formam-se focos profundos de necrose. De cima eles são cobertos com revestimento purulento ou cinza-amarelo e causam dor com leve toque. Os seguintes sintomas são observados:
- alta temperatura corporal;
- inchaço grave do pênis;
- hiperemia da pele;
- fraqueza
- às vezes náusea e vômito;
- os linfonodos inguinais aumentam.
Devido a danos nos vasos sanguíneos nos estágios posteriores, o sangramento aparece e a proliferação do tecido conjuntivo leva à deformação do pênis. Células mortas são difíceis de reparar, em seu lugar formam-se aderências, cicatrizes ou cicatrizes.
Causas da inflamação do prepúcio em homens
A balanopostite desenvolve-se com a interação de várias causas e fatores predisponentes. As seguintes doenças causam inflamação:
- tricomoníase;
- papilomavírus humano;
- candidíase;
- gonorréia;
- sífilis;
- clamídia
- vírus do herpes;
- infecção por estreptococos e estafilococos.
Fatores predisponentes incluem:
- doenças infecciosas dos rins, bexiga;
- doenças alérgicas;
- imunidade diminuída;
- psoríase
- diabetes mellitus;
- líquen plano;
- vestindo roupas íntimas feitas de materiais sintéticos;
- dieta desequilibrada;
- violação de regras de higiene;
- o uso de lubrificantes, detergentes com substâncias agressivas na composição;
- características anatômicas dos órgãos genitais masculinos;
- alta atividade sexual.

Diagnóstico
O paciente é examinado por um urologista, alergista, dermatologista, venereologista. Na primeira etapa, o médico realiza um exame geral do paciente, coleta um histórico médico, ouve reclamações. Para determinar a causa da inflamação, são prescritos testes padrão e métodos de diagnóstico instrumental:
- Cultura bacteriana e PCR (reação em cadeia da polimerase). O tipo de patógeno é determinado por um fragmento do biomaterial.
- Testes de sangue e urina. Determina o estado geral do corpo, revela diabetes mellitus e doenças inflamatórias dos rins.
- Testes alérgicos. A sensibilidade do corpo a várias substâncias é determinada.
- Exame ultrassonográfico Apontado para identificar selos nos tecidos do corpo e esclarecer sua localização.
- Análise de infecções genitais latentes. Detecta a presença de sífilis, clamídia e outras doenças.
- Antibioticograma. Detecta a sensibilidade dos microrganismos a um grupo específico de antibióticos.
Tratamento de balanopostite
Formas agudas e crônicas da doença são tratadas de maneira conservadora. O paciente recebe medicamentos sistêmicos e locais que eliminam sintomas desagradáveis e a causa da inflamação. O complexo de medidas terapêuticas também inclui:
- fisioterapia - melhorar o tecido trófico, aliviar o inchaço;
- dissecação da carne, seguida pela circuncisão - é prescrito para fimose;
- saneamento dos gânglios linfáticos (com inflamação avançada) - para prevenir novas infecções da bexiga e da próstata.
Terapia medicamentosa
A escolha das táticas de tratamento depende da causa da balanopostite nos homens:
- Se a inflamação é causada por vírus, prescreva pílulas para fortalecer a imunidade e combater os micróbios - Ribavirina, Arbidol.
- Com balanopostite fúngica, os antimicóticos sistêmicos locais são usados: Fluconazol, Lamisil, Nistatina, Clotrimazole.
- A forma alérgica da doença é tratada com anti-histamínicos - Loratadin, Suprastin. Em casos graves, pomadas hormonais são prescritas - Prednisolona, Advantan.
- Para acelerar o tratamento, banhos com soluções são feitos todas as noites. permanganato de potássio, furatsilinom, clorexidina.

Drogas antibacterianas
Se a flora bacteriana for detectada, os antimicrobianos são incluídos no regime de tratamento.
- gonocócico - Pantsef, Ciprofloxacina.
- Trichomonas Metronidazol, Trichopolum, Metrogil.
- inflamação bacteriana não específica - Cefazolina, eritromicina.
- candida - Fluconazol, Diflucan, Flucostat.
- herpes Aciclovir, Zovirax.
Instalações ao ar livre

Drogas locais têm efeitos analgésicos, antipruriginosos e antiinflamatórios. Os seguintes medicamentos são recomendados:
- Pomada Levomekol. Suprime a reprodução da flora patogênica, acelera o processo de regeneração. O unguento é usado para curativos, injetado na cavidade purulenta através de um cateter.
- Creme Triderm. Reduz o inchaço dos tecidos moles, alivia a coceira e reduz a inflamação. Aplique na área afetada 2 vezes ao dia.
- Solução de miramistina. Tem propriedades anti-sépticas, reduz a inflamação, alivia a coceira. Usado para banhos, irrigação e compressas.
Intervenção cirúrgica para balanopostite
O tratamento cirúrgico é indicado em casos graves se:
- A inflamação não pode ser eliminada por métodos conservadores. A operação é executada quando o estágio agudo diminui.
- A formação de fimose cicatricial começou.
A circuncisão do prepúcio é prescrita em toda a circunferência do pênis. A operação é realizada por um cirurgião ou urologista sob anestesia local. As bordas da ferida são suturadas por uma sutura absorvível.A circuncisão é contra-indicada na fusão da cabeça e do prepúcio.
Remédios populares para inflamação do prepúcio
Receitas de decocções e infusões de ervas eficazes nas etapas iniciais da doença:
- Folhas de aloé se livrar de espinhos, enxaguar. Remova a camada superior com uma faca. Anexar a área exposta à área inflamada, fixe com uma bandagem. Mude os curativos 2 vezes ao dia.
- Despeje 2 colheres de sopa. l sábio 500 ml de água fervente. Insista 3 horas, tensão. Mergulhe um cotonete com uma solução e fixe-o à área afetada por 20 minutos. Coloque compressas 2-3 vezes ao dia.
- Misture 1 colher de sopa. l calêndula e 100 ml de azeite. Insistir 2 semanas. Lubrifique a pele inflamada 2 vezes ao dia.

Prevenção
Para evitar balanopostite, siga estas recomendações:
- Lave a cabeça do pênis e prepúcio com água morna 2 vezes ao dia. Realize procedimentos de higiene antes e depois do contato sexual.
- Sempre use preservativo durante o sexo com um novo parceiro.
- Use detergentes hipoalergênicos.
- Visite o seu médico regularmente para um exame de rotina, trate as doenças concomitantes de maneira oportuna.
Video
Balanite e balanopostite. Quais são as razões? Quais são os sintomas? Como tratar?